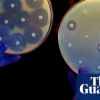

Viewing teamsnapzu's Snapzine
-
2851.

Natural gas is a much ‘dirtier’ energy source than we thought
Coal, oil, and gas are responsible for much more atmospheric methane, the super-potent warming gas, than previously known.
Posted in: by doodlegirl -
2852.

Amazon is opening its first full-size, cashierless grocery store. Here's a first look inside
Amazon is cracking further into the $800 billion U.S. grocery industry, keeping the likes of Walmart, Kroger, 7-Eleven and Instacart on their toes.
-
2853.

Pizza Hut Wants To Replace All Cheese With Vegan Alternative To Cut Emissions
Pizza Hut has revealed that it would like to replace all its dairy cheese with a vegan alternative one day as part of its plans to become more sustainable. While the chain says its does not envision taking dairy products off the menu in the 'near future', it is 'dedicated to evolving our practices and processes with the aim of making a more positive impact'.
Posted in: by zritic -
2854.

Google Warns Huawei Users Against Getting Its Apps From Other Places
Google wants to clear things up for Huawei device users: Google’s apps and services cannot be preloaded on new Huawei devices and are not available due to U.S. government restrictions. If users try to download Google apps and services through a side door, or essentially download them from somewhere other than the Play Store, bad things can happen.
Posted in: by baron778 -
2855.

Is There Anything Wrong With Being a Slow Reader?
Hours of each day pass where I encounter nothing truly memorable on my computer or phone. What was I just reading five minutes ago?
Posted in: by estherschindler -
2856.

New Music Release Tuesday - Week of February 19 - 25, 2020 (81 tracks)
Hey Snapzu, here's your newest mega-list of all new (English language) music releases/singles of this past week. Listen, enjoy, and don't forget to vote for your favorites so they climb on the list and stand out from the rest!
-
2857.

Genetically Engineered Bacteria Protect Honey Bees Against Parasites
In a new study published in the journal Science, researchers from The University of Texas at Austin outline their novel approach to protecting honey bees at risk of colony collapse – genetically engineered bacteria.
Posted in: by zyery -
2858.

Fusion startup claims breakthrough will provide "unlimited" energy
"I don't want to be a laughing stock by promising we can deliver something in 10 years, and then not getting there."
Posted in: by kxh -
2859.

Could the coronavirus outbreak speed up the development of robo-deliveries?
As customer fears about the coronavirus cast a shadow over China’s food delivery industry, several companies including Meituan Dianping, JD.com and Ele.me have announced robot-delivery related services.
Posted in: by cone -
2860.

Researchers develop high-capacity EV battery materials that double driving range
Dr. Hun-Gi Jung and his research team at the Center for Energy Storage Research of the Korea Institute of Science and Technology (KIST, President Lee Byung Gwon) have announced the development of silicon anode materials that can increase battery capacity four-fold in comparison to graphite anode materials and enable rapid charging to more than 80% capacity in only five minutes. When applied to batteries for electric vehicles, the new materials are expected to more than double their driving range.
Posted in: by wetwilly87 -
2861.

YouTube Music will soon let you upload your own music
When Google first introduced YouTube Music, it promised to port over all Play Music features to it. The execution has been excruciatingly slow, but it
-
2862.

Welcome to the Fresh Internet Hell of the Streaming Wars
No matter who wins, viewers are going to lose.
Posted in: by sjvn -
2863.

How to Write Usefully
What should an essay be? Many people would say persuasive. That's what a lot of us were taught essays should be. But I think we can aim for something more ambitious: that an essay should be useful.
-
2864.
Powerful antibiotic discovered using machine learning for first time
Team at MIT says halicin kills some of the world’s most dangerous strains
Posted in: by darvinhg -
2865.

MRIs reveal smartphone addiction physically changes brains
Your iPhone addiction might be creating physical changes in your brain, according to a new study. Researchers looked into smartphone addiction and how it correlates to structural and functional changes in the brain. They conducted MRI scans on 48 people, 22 of whom had smartphone addiction (SPA). The study found that SPA alters the brain in a way similar to what doctors see in drug addicts. The findings only get worse from there.
Posted in: by kong88 -
2866.

Twitter is testing new ways to fight misinformation — including a community-based points system
A leaked demo features bright red and orange badges for tweets that have been deemed “harmfully misleading."
Posted in: by funhonestdude -
2867.

How Saudi Arabia Infiltrated Twitter
“Proactive and reactively we will delete evil my brother.”
Posted in: by 8mm -
2868.

Rapper Pop Smoke Dead, Murdered in Home Invasion
Sources familiar with the surveillance video tell TMZ ... the video shows at least 4 masked men with hoodies making their way into the house just 10 minutes after people inside the house deadbolted the front doors shut. We're told they did not turn the house alarm on, which made it easier for the home invaders to get inside.
Posted in: by aj0690 -
2869.

Living Off-Grid Seemed Like Fun Until I Tried it
We emerged like miners rescued from the dark pits of the earth and vowed: never again.
Posted in: by rawlings -
2870.

Wikipedia Is the Last Best Place on the Internet
People used to think the crowdsourced encyclopedia represented all that was wrong with the web. Now it's a beacon of so much that's right.
Posted in: by ppp -
2871.

Kickstarter workers vote to form first union in tech industry
The historic vote comes amid growing discontent among employees at technology companies such as Google, Amazon and Microsoft, who have started to organize.
Posted in: by geoleo -
2872.

Tesla teardown finds electronics 6 years ahead of Toyota and VW
Toyota Motor and Volkswagen each sell 10 million cars, give or take, every year. Tesla delivered about 367,500 in 2019. But when it comes to electronics technology, Elon Musk's scrappy company is far ahead of the industry giants. This is the takeaway from Nikkei Business Publications' teardown of the Model 3, the most affordable car in the U.S. automaker's all-electric lineup, starting at about $33,000.
Posted in: by larylin -
2873.

They Sold Human Beings Here
For hundreds of years, enslaved people were bought and sold in America. Today most of the sites of this trade are forgotten. As part of The 1619 Project, we photographed 12 of them.
Posted in: by grandtheftsoul -
2874.

Astronomers to sweep entire sky for signs of extraterrestrial life
Project is collaboration between privately-funded firm and New Mexico observatory
Posted in: by socialiguana -
2875.

Did coronavirus originate in Chinese government laboratory?
A new bombshell paper from the Beijing-sponsored South China University of Technology says that the Wuhan Center for Disease Control could have spawned the contagion in Hubei.
Posted in: by belangermira -
2876.

NASA created a new chainmail tire that can transform its shape
NASA Glenn Research Center has just reinvented the wheel, introducing a new tire that can get back to its original shape after having undergone deformation. This invention was possible thanks to a shape memory alloy based on nickel-titanium.
Posted in: by aj0690 -
2877.

Local Bookstores Have A New Weapon In The Fight With Amazon
Bookshop.org is looking to generate revenue for independent book stores by moving sales, and affiliate links, away from Amazon and toward independent bookstores.
Posted in: by geoleo -
2878.

People With Depression May Find Sad Memes Funnier And More Uplifting
Memes have become an integral part of online communication — and a ripe area for research. Underlying the simplicity of a grainy picture and a few words of text are countless more complex psychological questions. What determines why some memes go viral? How do they shape people’s political or social views? And in what ways do our perceptions of memes change depending on our personalities — or even on our mental health?
Posted in: by geoleo -
2879.

Amazon can’t end fake reviews, but its new system might drown them out
The company’s new one-tap star rating feature seeks to get more customer feedback ... from actual customers.
Posted in: by TNY -
2880.

Los Angeles uses tech to wipe out 66,000 old pot convictions
Los Angeles County prosecutors are joining other district attorneys to use technology to wipe out or reduce as many as 66,000 old marijuana convictions years after California voters broadly legalized the drug. The county is working with the Code for America nonprofit tech organization, which uses computer algorithms to find eligible cases that are otherwise hard to identify in decades-old court documents. The group has offered its Clear My Record technology free to all 58 state district attorneys.
Posted in: by wetwilly87




















